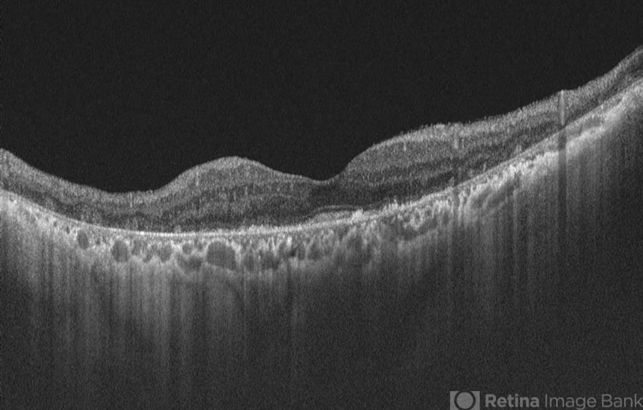

-
 By Hemanth Murthy, MBBS, MD, FASRS
By Hemanth Murthy, MBBS, MD, FASRS
RETINA INSTITUTE OF KARNATAKA
Co-author(s): Dr Shivani SM - Uploaded on Sep 25, 2025.
- Last modified by Joshua Friedman on Sep 26, 2025.
- Rating
- Appears in
- Miscellaneous
- Condition/keywords
- acute zonal occult outer retinopathy (AZOOR)
- Photographer
- Mr Veda Vyas
- Imaging device
- Optical coherence tomography system
- Description
- OCT image of right eye of a 72 yr male with history of progressive loss of vision and loos of field of vision more in right eye. It shows a tribunal pattern of outer retina loss

Initializing download.
Initializing download.









